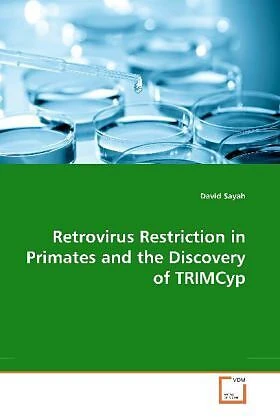

Wir verwenden Cookies und Analyse-Tools, um die Nutzerfreundlichkeit der Internet-Seite zu verbessern und für Marketingzwecke. Wenn Sie fortfahren, diese Seite zu verwenden, nehmen wir an, dass Sie damit einverstanden sind. Zur Datenschutzerklärung.
Retrovirus Restriction in Primates and the Discovery of TRIMCyp
Details
Cells derived from numerous primate species are known to resist HIV-1 infection, a finding that had limited the development of non-human primate models of AIDS. In recent years, several studies suggested that many primate-derived cell lines possess dominant factors that block infection by various retroviruses. In the work described here, one of these factors was identified as a protein named TRIM-Cyp. In addition to its potent ability to interfere with HIV infection, TRIM-Cyp also represents an important mechanism in the formation of new genes - it is a hybrid between two unrelated genes, created by the activity of a retrotransposon. TRIM-Cyp, and other TRIM5 proteins in various primates, are important determinants of retrovirus tropism, and reveal a great deal about the evolutionary arms race between retroviruses and their hosts.
Autorentext
David Sayah is currently a resident physician in San Francisco. The research described here was completed while he was a graduate student at Columbia University in New York City.
Weitere Informationen
- Allgemeine Informationen
- GTIN 09783836471077
- Sprache Deutsch
- Genre Weitere Biologie-Bücher
- Größe H220mm x B150mm x T10mm
- Jahr 2012
- EAN 9783836471077
- Format Kartonierter Einband
- ISBN 978-3-8364-7107-7
- Veröffentlichung 06.12.2012
- Titel Retrovirus Restriction in Primates and the Discovery of TRIMCyp
- Autor David Sayah
- Gewicht 233g
- Herausgeber VDM Verlag Dr. Müller e.K.
- Anzahl Seiten 144